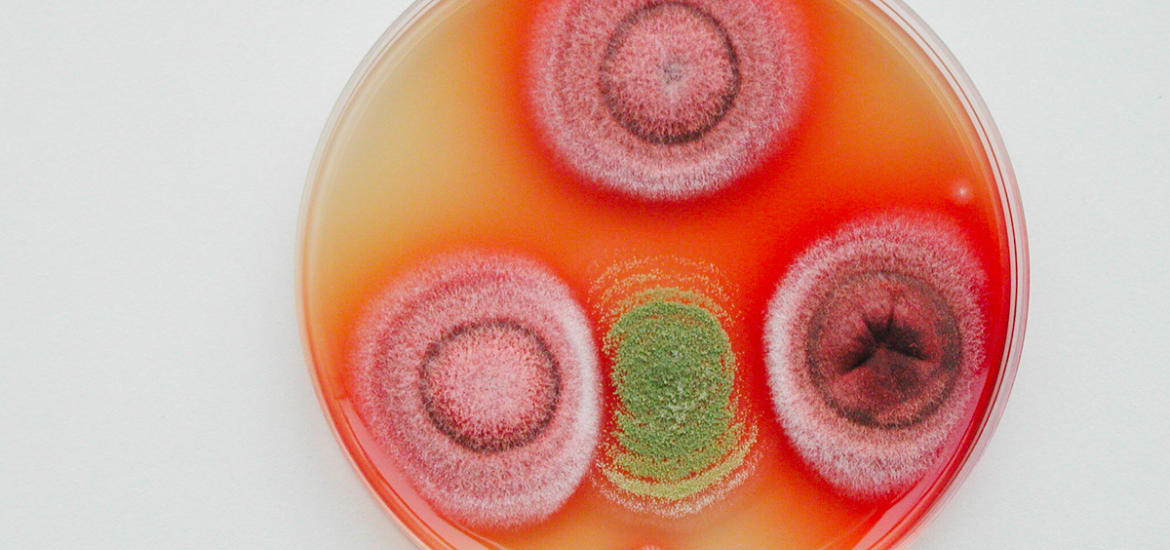
equasa.png

Notre mission: Études en qualité et sécurité des aliments
EQUASA met son expertise en microbiologie (mycologie et bactéries sporulées) au service des entreprises des secteurs agro-alimentaires, cosmétique, environnement. Cette expertise s’appuie sur celle des enseignants-chercheurs de l’ESIAB/LUBEM et sur l’accès à la collection de micro-organismes de l’UBOCC.
EQUASA propose ainsi des prestations de services à façon :
- Isolement par culture et identification/caractérisation morphologique et/ou moléculaire de champignons et de bactéries sporulées,
- Données expertes sur les micro-organismes étudiés (origine, risques associés…),
- Bilans de contamination d’air et de surfaces (industries, habitat,...),
- Quantification de micro-organismes technologiques et/ou contaminants
- Caractérisation de communautés par métabarcoding,
- Validation de procédés et de produits (challenge-tests, tests de vieillissement, efficacité de solutions de décontamination, de bioprotection),
- Production d’inoculum
EQUASA dispose de l’ensemble des moyens techniques d’un laboratoire de microbiologie.
Nos domaines d'expertise:
- Mycologie
- Moisissures
- Bactéries sporulées
- Contaminant
- Qualité
- Agro-alimentaire
- Agriculture
- Environnement
Directeur :
Gaétan LE FLOC'H
Adresse :
Centre de Ressources EQuASA ESIAB Technopôle Brest Iroise
29280 PLOUZANE - FRANCE